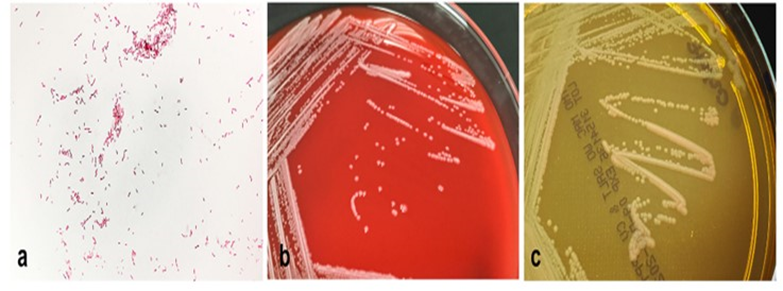

Cuando se presenta un paciente con queratitis, generalmente los profesionales se hacen una idea del microorganismo que la está causando, teniendo en cuenta el cuadro clínico y las infecciones comúnmente encontradas. Sin embargo, los patógenos potencialmente infecciosos para la córnea son muy diversos y su manifestación dependerá también de la región geográfica. Se ha establecido que 1 de cada 20 casos puede tratarse de un microorganismo poco común y se debe prestar especial atención al respecto, ya que el diagnóstico demorado evita el tratamiento oportuno. (1)
En esta ocasión, se abordará la queratitis por Achromobacter xylosoxidans, microorganismo que se ha catalogado como raro, pero causante emergente de queratitis. Se trata de un bacilo aeróbico gran negativo, móvil, no fermentador. La posible razón por la que está afectando más a la córnea, es que se transmite a través del agua y suele encontrarse en entornos húmedos como piscinas, lagos, ríos, suelos, humidificadores, fregaderos y desagües. También se ha descrito que esta bacteria es oportunista provocando infecciones en humanos inmunosuprimidos. En cuanto a la salud general, se afirma que esta bacteria es causante de infecciones en el tracto respiratorio en pacientes con fibrosis quística, el tracto urinario en pacientes con sondas urinarias y la bacteriemia en pacientes sometidos a quimioterapia. Aunque no se ha reportado un gran número de casos de queratitis por esta entidad, también se cree que puede estar subestimada la incidencia real por dificultad en el diagnóstico. (1)(2)
Aunque no se conoce con certeza la patogénesis de la infección por Achromobacter xylosoxidans, se han establecido factores de riesgo como: cirugías corneales previas, uso de lentes de contacto, aplicación de corticosteroides tópicos, lesiones oculares y enfermedad de la superficie ocular. Lo que fundamentalmente debe importar, es que esta bacteria tiene la capacidad de resistir ante el sistema inmune, y también es resistente a diversos antibióticos y sistema de desinfección. Esto es posible gracias a su habilidad para secretar sustancias poliméricas extracelulares para formar biopelículas, a las proteínas de resistencia-nodulación-división celular que conforman una bomba de eflujo de medicamentos en la membrana citoplasmática, y a la codificación cromosómica de betalactamasas de espectro estrecho clase D. (1)(3)
En el cuadro semiológico, se describe que la severidad de la queratitis puede variar. Los síntomas incluyen dolor, fotofobia, hiperemia conjuntival y disminución de la agudeza visual. Los signos clínicos están acordes con la invasión por entidades gramnegativas en términos de edema palpebral, infiltrados corneales, defectos epiteliales, reacción inflamatoria en la cámara anterior, meltig corneal, hipopión y necrosis estromal. Debido al parecida con otros bacilos gramnegativos, en los medios de cultivo convencionales como el agar sangre, agar chocolate y agar MacConkey, las especies de Achromobacter típicamente desarrollan colonias planas y puntiformes que se expanden. Estas bacterias presentan flagelos perítricos, lo cual puede ser útil para distinguirlas de las especies de Pseudomonas. Cuando el diagnóstico es aún impreciso, las plataformas modernas de espectrometría de masas, será definitiva con una confiabilidad muy alta. (1) Ver Figuras 1 y 2.
Figura 1. Queratitis por Achromobacter xylosoxidans. Obsérvese el infiltrado profundo y la inclusión epitelial. (3)

Figura 2. Identificación de Achromobacter xylosoxidans. A. Microscopía óptica. B. Cultivo en agar sangre. C. Cultivo en agar MacConkey.
En cuanto al tratamiento, este puede ser complejo por la resistencia propia de la bacteria. El tratamiento empírico puede ser desfavorable. Se ha afirmado que para la Achromobacter xylosoxidans generalmente se requiere el uso de antibióticos tópicos como amikacina, ceftazidima, penicilinas de amplio espectro, imipenem, meropenem, polimixina y trimetoprim. La resistencia bacteriana se ha observado frente a las cefalosporinas de primera generación y a los aminoglucósidos. Las sensibilidades a diferentes fluoroquinolonas, que son frecuentemente empleadas en el tratamiento empírico, pueden ser variables. Especialmente se ha reportado susceptibilidad a las fluoroquinolonas de nueva generación como moxifloxacino. También se ha mostrado la posibilidad de uso de antibióticos intraestromales cuando la infiltración es marcada y/o profunda. Como se mencionó dependiendo de la severidad, el tratamiento también abarcará abordajes como queratoplastias terapéuticas, y crosslinking. Por lo anterior, diagnosticar la queratitis por Achromobacter xylosoxidans oportunamente es esencial para un tratamiento eficaz y para prevenir complicaciones graves, como la pérdida de la visión. Por esta razón, cobra alta importancia el uso de métodos de cultivo y de identificación de patógenos avanzados.1,3
Referencias
- Ong HS, Sharma N, Phee LM, Mehta JS. Atypical microbial keratitis. Ocular Surface. 2023 Apr 1;28:424–39.
- Seo W, Chiu GB, She RC. Bacteriostatic Effect of Multidose Preservative-free Buffered Saline Used in Scleral Lens Wear. Optometry and Vision Science. 2020 Mar 1;97(3):162–8.
3. Castro Casal N, Viña Vázquez S, Romeo Villadóniga S. Achromobacter xylosoxidans keratitis in a LASIK flap treated with intrastromal antibiotics: a case report. Archivos de la Sociedad Española de Oftalmología (English Edition). 2024 Jun

